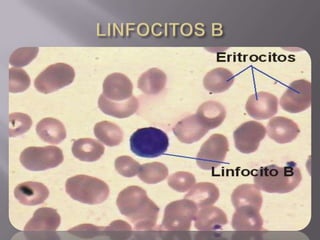

El documento resume el sistema linfoide y sus componentes. El sistema linfoide protege el cuerpo contra invasores mediante sus células y órganos. Incluye la segunda y tercera línea de defensa contra patógenos. Reconoce y combate antígenos de manera específica a través de linfocitos. Sus componentes celulares incluyen neutrófilos, células NK, macrófagos y linfocitos T y B.